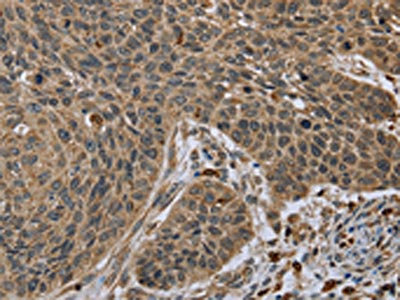
CSB-PA984896

TNFRSF13C
TNFRSF13C,也稱為BAFFR,是一種膜蛋白,屬于TNF受體超家族。它主要在B細胞上表達,對于B細胞的存活和活化至關重要。BAFFR與BAFF結合,可以促進B細胞的增殖和分化,并在免疫系統中發揮重要作用。與BAFFR相關的疾病包括自身免疫性疾病和某些類型的免疫缺陷。在藥物研發方面,針對BAFFR的藥物正在開發中,旨在治療這些疾病。
熱銷產品
驗證數據

(Tris-Glycine gel) Discontinuous SDS-PAGE (reduced) with 5% enrichment gel and 15% separation gel.

Activity
Measured by its binding ability in a functional ELISA. Immobilized TNFSF13B (CSB-MP897523HU1) at 2 μg/ml can bind TNFRSF13C, the EC50 is 9.943-15.72 ng/ml.

Activity
Measured by its binding ability in a functional ELISA. Immobilized human TNFRSF13C at 2 μg/ml can bind Biotinylated human TNFSF13B (CSB-MP897523HU1-B), the EC50 is 0.2699-0.5613 ng/ml.
TNFRSF13C Antibody (CSB-PA984896)
驗證數據

The image on the left is immunohistochemistry of paraffin-embedded Human thyroid cancer tissue using CSB-PA984896(TNFRSF13C Antibody) at dilution 1/45, on the right is treated with synthetic peptide. (Original magnification: ×200)
The image on the left is immunohistochemistry of paraffin-embedded Human lung cancer tissue using CSB-PA984896(TNFRSF13C Antibody) at dilution 1/45, on the right is treated with synthetic peptide. (Original magnification: ×200)

Gel: 10%SDS-PAGE, Lysate: 40 μg, Lane: Mouse thymus tissue, Primary antibody: CSB-PA984896(TNFRSF13C Antibody) at dilution 1/300, Secondary antibody: Goat anti rabbit IgG at 1/8000 dilution, Exposure time: 2 minutes
TNFRSF13C Antibodies
TNFRSF13C for Homo sapiens (Human)
| 產品貨號 | 產品名稱 | 種屬反應性 | 應用類型 |
|---|---|---|---|
| CSB-PA853495LA01HU | TNFRSF13C Antibody | Human | ELISA |
| CSB-PA853495LC01HU | TNFRSF13C Antibody, FITC conjugated | Human | |
| CSB-PA853495LD01HU | TNFRSF13C Antibody, Biotin conjugated | Human | ELISA |
| CSB-PA984896 | TNFRSF13C Antibody | Human,Mouse | ELISA,WB,IHC |
| CSB-PA249091 | TNFRSF13C Antibody | Human,Mouse | ELISA,IHC |
TNFRSF13C Proteins
TNFRSF13C Proteins for Homo sapiens (Human)
| 產品貨號 | 產品名稱 | 來源 |
|---|---|---|
| CSB-YP853495HU CSB-EP853495HU CSB-BP853495HU CSB-MP853495HU CSB-EP853495HU-B |
Recombinant Human Tumor necrosis factor receptor superfamily member 13C (TNFRSF13C), partial | Yeast E.coli Baculovirus Mammalian cell In Vivo Biotinylation in E.coli |
| CSB-AP002181HU | Recombinant Human Tumor necrosis factor receptor superfamily member 13C protein (TNFRSF13C), partial (Active) | E.Coli |
| CSB-MP853495HU1 | Recombinant Human Tumor necrosis factor receptor superfamily member 13C (TNFRSF13C), partial (Active) | Mammalian cell |
TNFRSF13C Proteins for Mus musculus (Mouse)
| 產品貨號 | 產品名稱 | 來源 |
|---|---|---|
| CSB-YP884026MO CSB-EP884026MO CSB-BP884026MO CSB-MP884026MO CSB-EP884026MO-B |
Recombinant Mouse Tumor necrosis factor receptor superfamily member 13C (Tnfrsf13c), partial | Yeast E.coli Baculovirus Mammalian cell In Vivo Biotinylation in E.coli |
TNFRSF13C ELISA Kit
TNFRSF13C ELISA Kit for Mus musculus (Mouse)
| 產品貨號 | 產品名稱 | 樣本類型 | 靈敏度 |
|---|---|---|---|
| CSB-EL023972MO | Mouse Tumor necrosis factor receptor superfamily member 13C(TNFRSF13C) ELISA kit | serum, plasma, tissue homogenates | 9.75 pg/ml |












